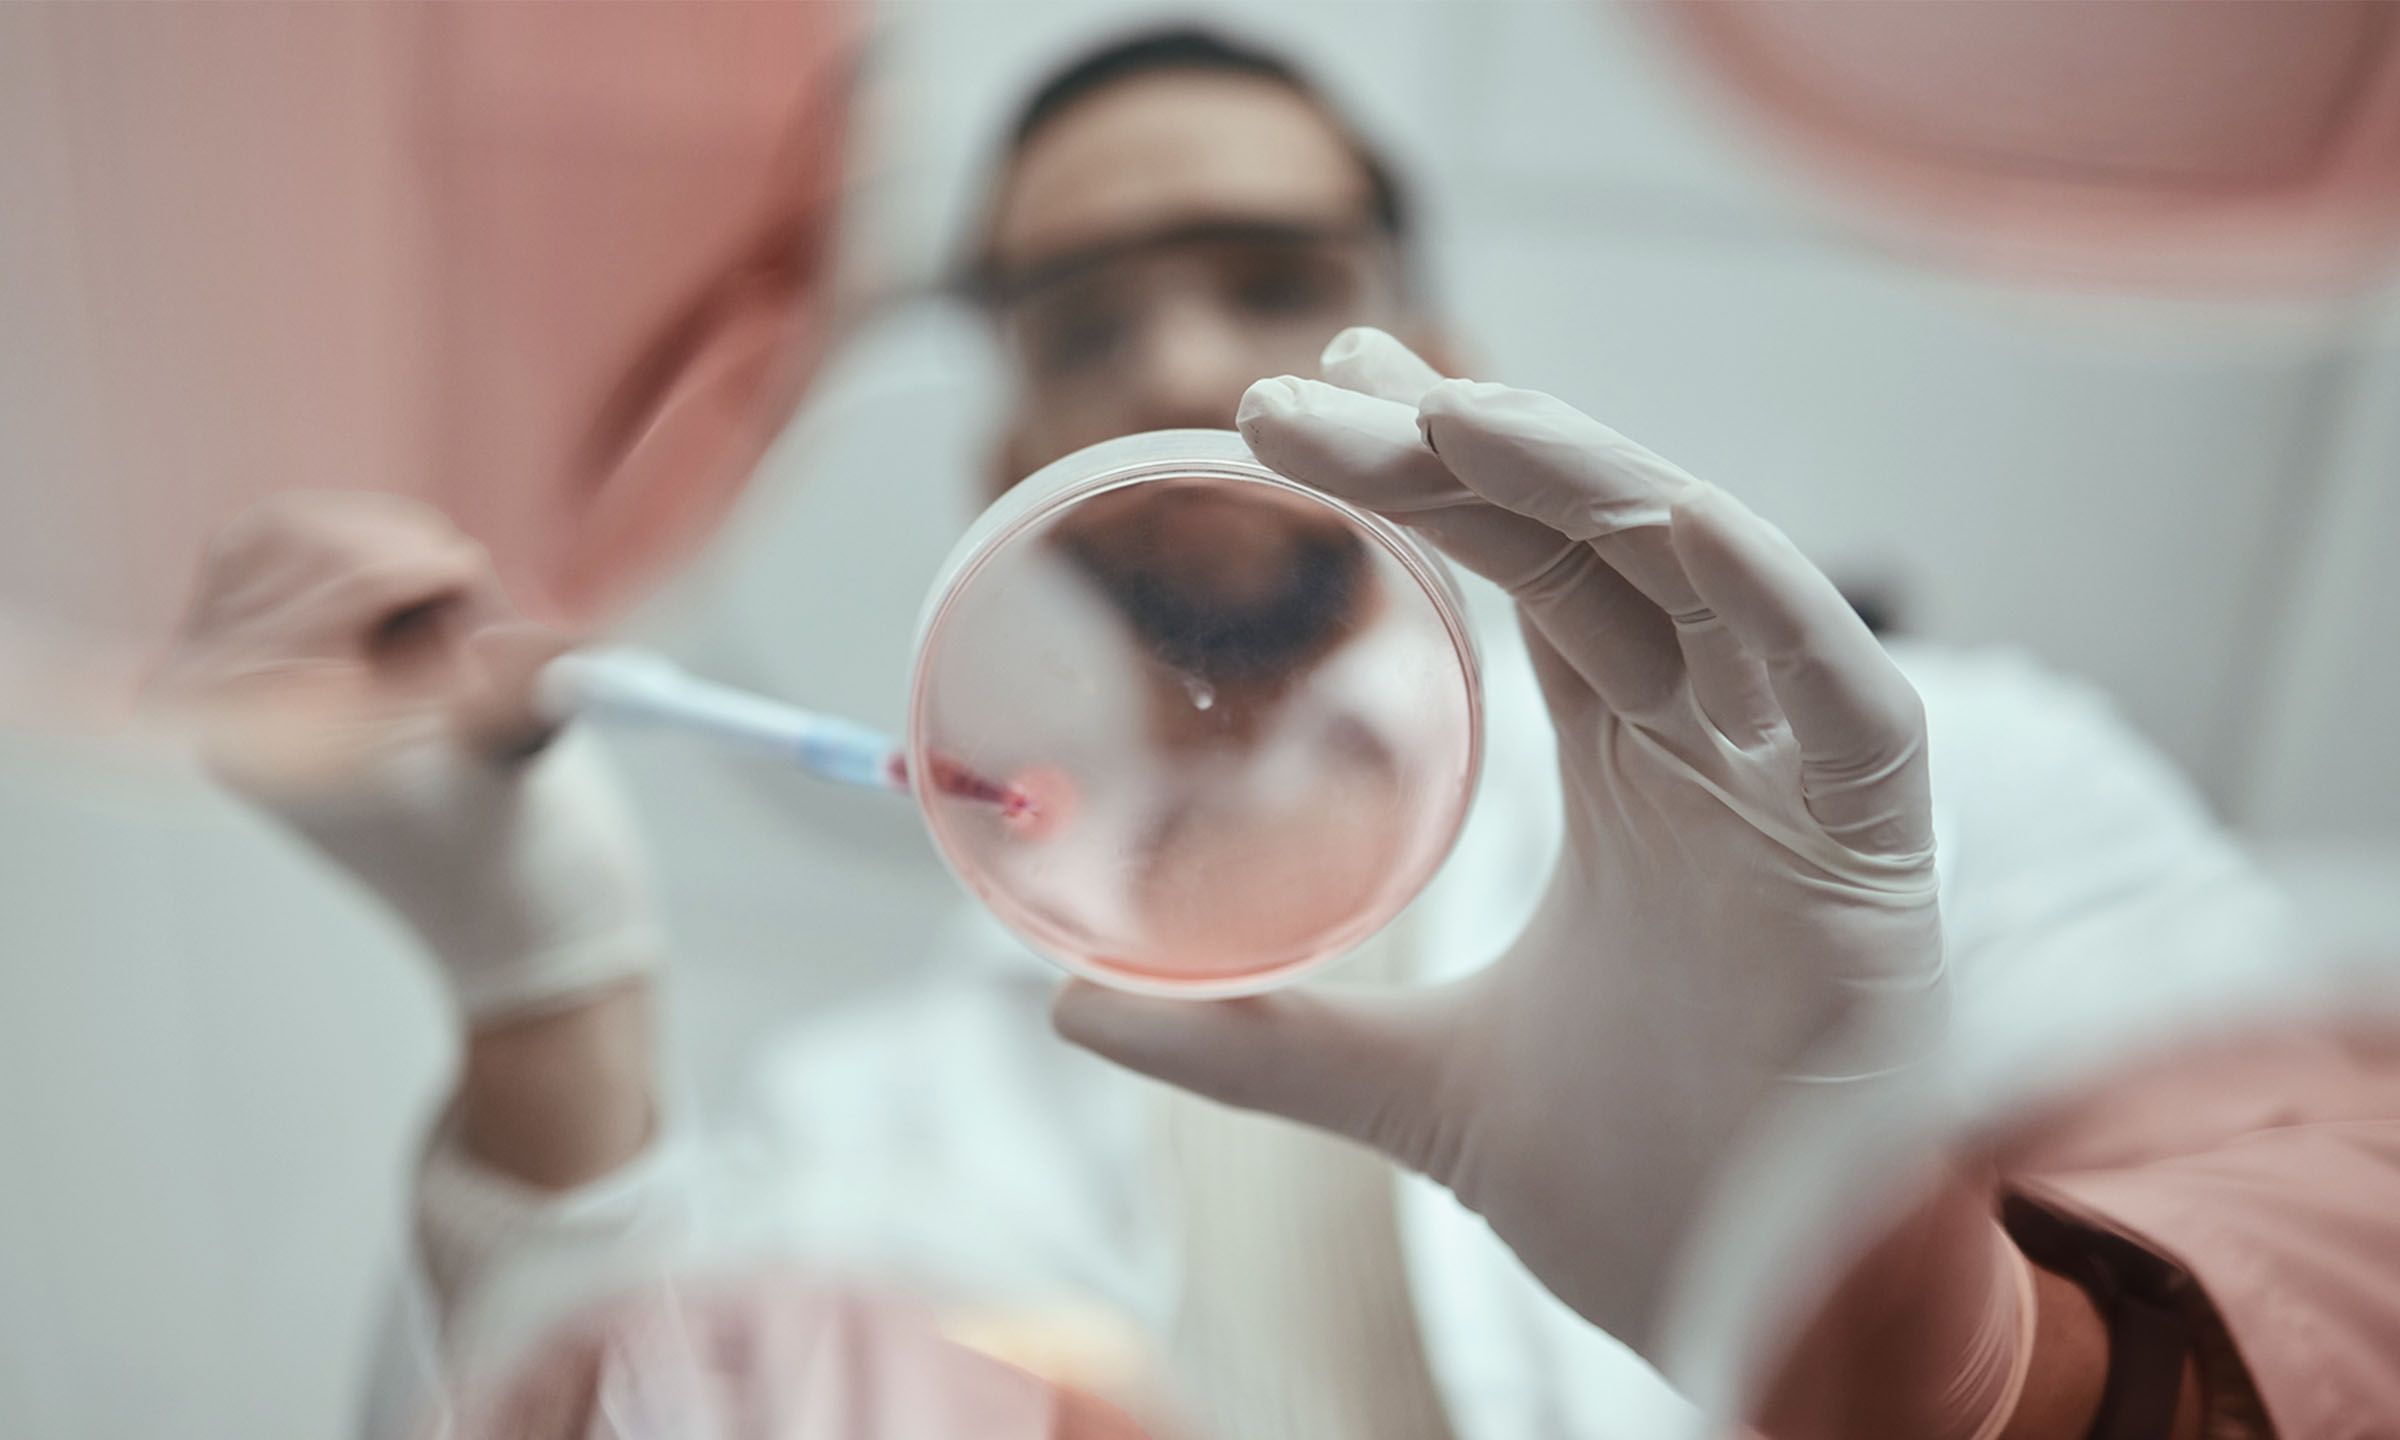

Articles
Breakthrough or bust: Why biopharma can’t afford to transform slowly
Why now? In 2025, biopharma is caught in a squeeze. R&D costs are soaring. Timelines are slipping. Regulatory reform is tightening margins. Add the expiry of blockbuster patents and a…
Why now?
In 2025, biopharma is caught in a squeeze.
R&D costs are soaring. Timelines are slipping. Regulatory reform is tightening margins. Add the expiry of blockbuster patents and a surge in biosimilar competition, and the stakes for innovation have never been higher.
Meanwhile, many organisations remain trapped in legacy operating models—unable to translate scientific potential into enterprise value. Too many teams are still “working hard,” but not “moving fast.”
The signal is clear: the market no longer rewards effort. It rewards results.
Breakthrough isn’t a buzzword – it’s a benchmark
At Elixirr, we define breakthrough as results that wouldn’t happen without a fundamental shift. For biopharma leaders, that means:
- Accelerating product development timelines—not just hitting milestones, but recovering slipped timelines and achieving first-to-market advantage.
- Gaining earlier-than-projected FDA or EMA approvals—by embedding regulatory fluency into clinical strategy.
- Achieving compliance at lower cost—while navigating complex, global regulatory demands.
- Improving financial performance—even amid the margin compression of drug pricing reform.
- Boosting analyst confidence and strategic clarity—through outcome-driven transformation, not incrementalism.
Three ways to unlock breakthrough performance
1. Rethink how R&D delivers
Productivity isn’t just a pipeline issue. It’s a design challenge.
We help clients streamline clinical development, align cross-functional teams, and recover critical milestones—often reducing development time by over a year and doubling the number of compounds progressing to development.
2. Make your culture AI-ready
AI is already reshaping R&D—from antibody design to trial simulation. But without a shift in organisational mindset, trust, and adoption, the tools alone don’t deliver.
Breakthrough performance requires leadership alignment, cultural readiness, and intentional talent transformation.
3. Turn compliance into competitive advantage
The Inflation Reduction Act and global reforms are rewriting the rules.
We help clients embed compliance into operational design, so regulatory rigour becomes an enabler of speed and credibility—not a barrier.
The takeaway
In today’s biopharma landscape, transformation must be specific, urgent, and ROI-driven. There’s no appetite for theoretical consulting. Only for outcomes that speak for themselves.
Breakthrough results aren’t optional anymore—they’re imperative.
If that’s what your next quarter demands, we should talk.




